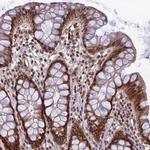
REXO1 Antibody in Immunohistochemistry (IHC)

Search
Invitrogen
REXO1 Polyclonal Antibody
{{$productOrderCtrl.translations['antibody.pdp.commerceCard.promotion.promotions']}}
{{$productOrderCtrl.translations['antibody.pdp.commerceCard.promotion.viewpromo']}}
{{$productOrderCtrl.translations['antibody.pdp.commerceCard.promotion.promocode']}}: {{promo.promoCode}} {{promo.promoTitle}} {{promo.promoDescription}}. {{$productOrderCtrl.translations['antibody.pdp.commerceCard.promotion.learnmore']}}
产品信息
PA5-59894
种属反应
宿主/亚型
分类
类型
抗原
偶联物
形式
浓度
规格
纯化类型
保存液
内含物
保存条件
运输条件
RRID
产品详细信息
Immunogen sequence: PSGKYVVDNS RPPTDLEYDP LSNYSARHLS RASSRDERAA KRPRGSRGSE PYTPAPKKLC DPFGSCDARF SDSEDEAATV PGNEPTT
Highest antigen sequence identity to the following orthologs: Mouse - 72%, Rat - 70%.
靶标信息
REXO1, also named as EloA-BP1, ELOABP1, KIAA1138 and TCEB3BP1, is transcription elongation factor B polypeptide 3-binding protein 1. REXO1 did not affect either the rate of transcription elongation by RNA polymerase II or the transcriptional activity of TCEB3 in vitro. This gene is different to the REX1 which is an embryo stem cell marker.
仅用于科研。不用于诊断过程。未经明确授权不得转售。
篇参考文献 (0)
生物信息学
蛋白别名: EloA-BP1; Elongin-A-binding protein 1; REX1, RNA exonuclease 1 homolog; RNA exonuclease 1 homolog; Transcription elongation factor B polypeptide 3-binding protein 1; unnamed protein product
基因别名: EloA-BP1; ELOABP1; KIAA1138; REX1; REXO1; TCEB3BP1
UniProt ID: (Human) Q8N1G1
Entrez Gene ID: (Human) 57455